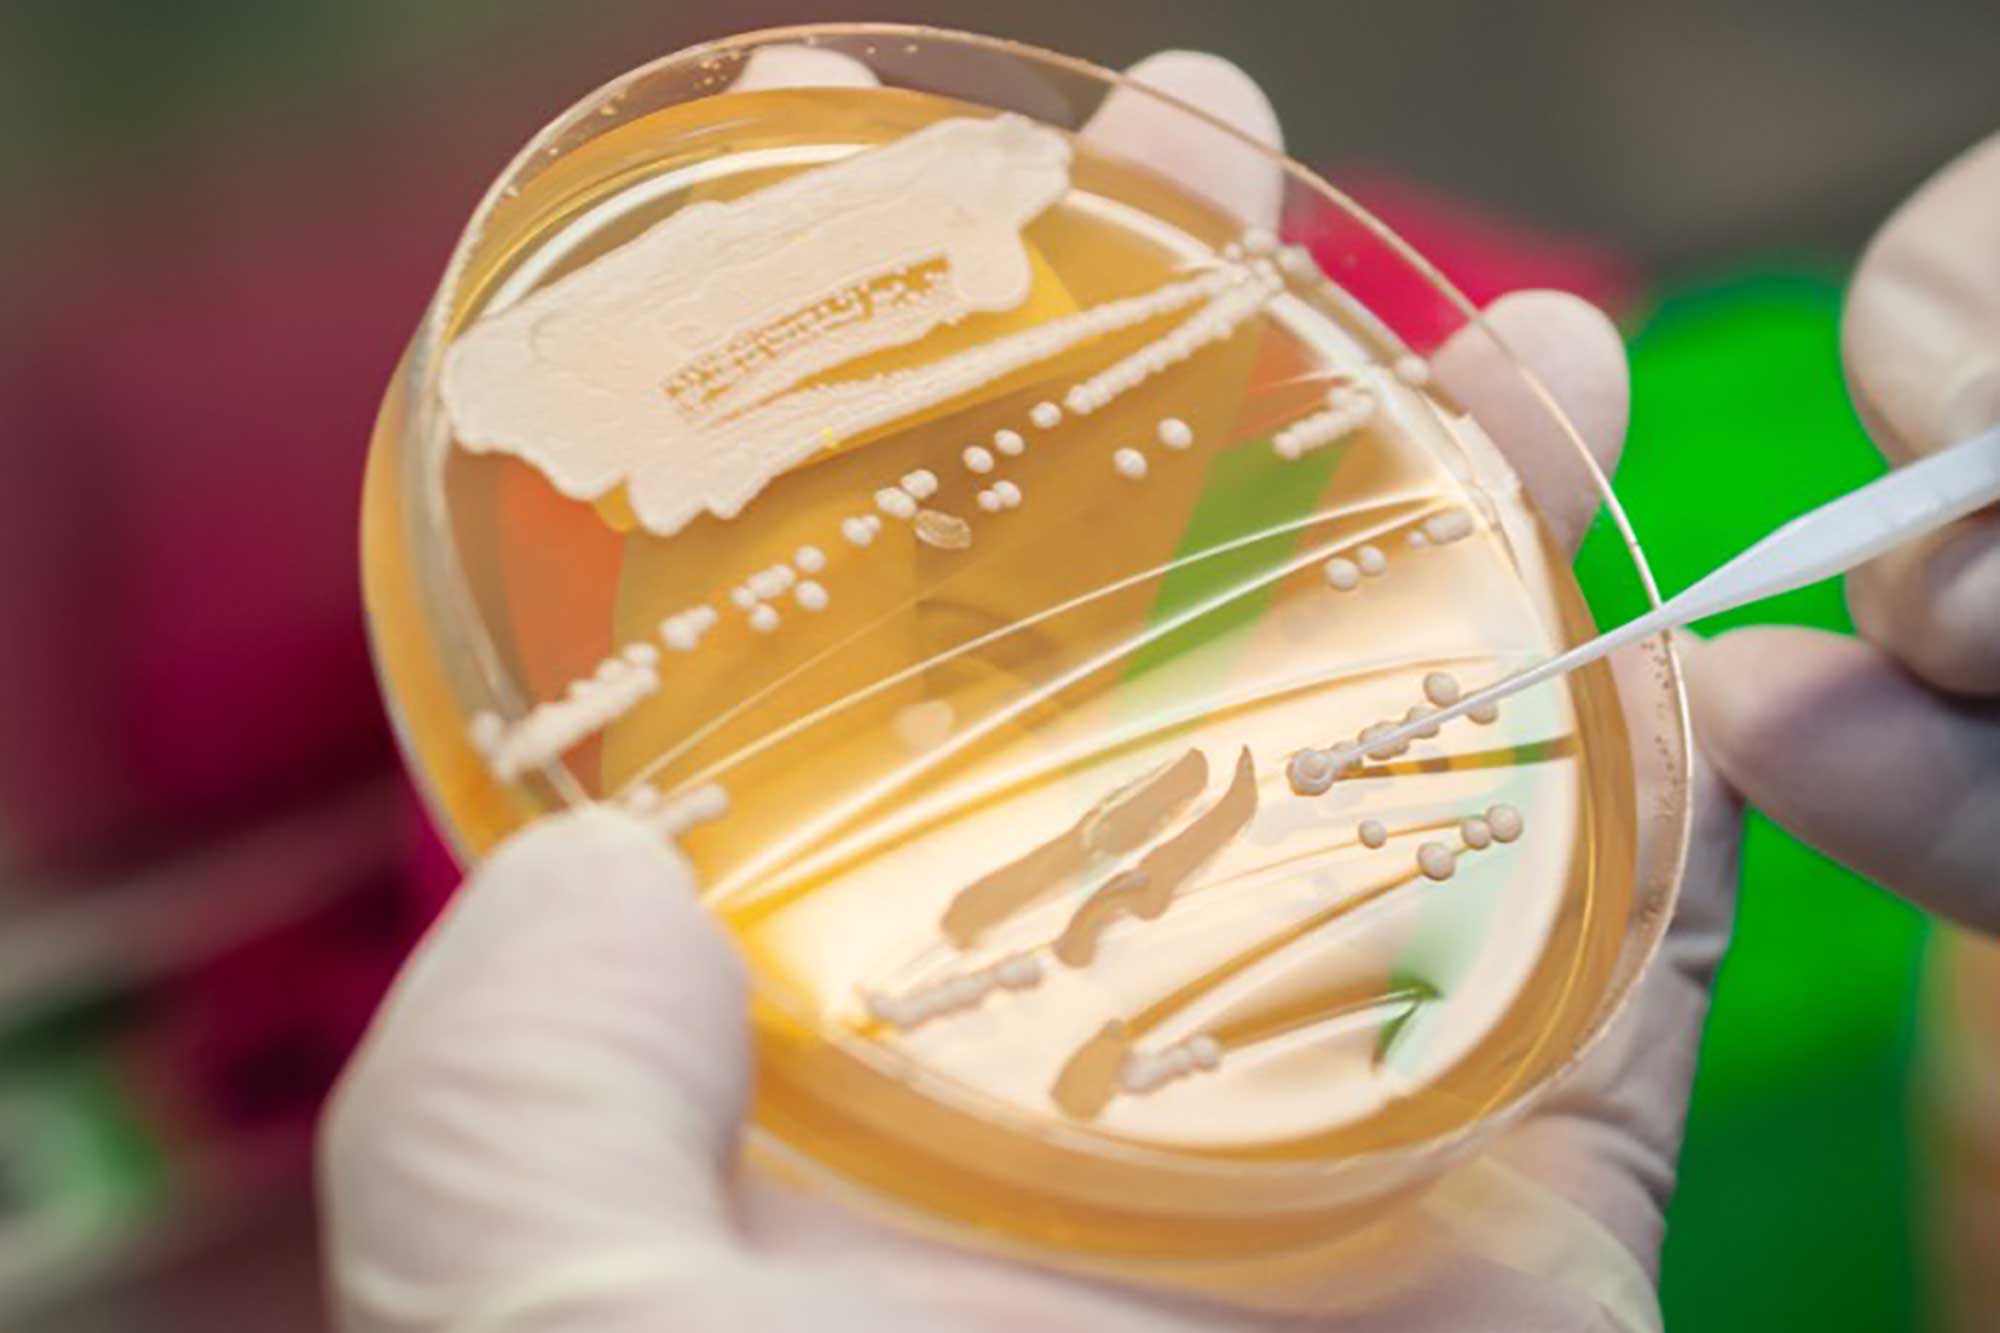
Unlock the Power of Yeast Blends in Crafting Unique Spirits

Not All Columns Are Created Equal
The term “column still” can apply to various designs with different purposes. To make sure you have the right still for the job, it’s best to understand the role and function of each of these types.
Showing 21-40 of 262 articles

The term “column still” can apply to various designs with different purposes. To make sure you have the right still for the job, it’s best to understand the role and function of each of these types.

When small distilleries have success, it can be tricky to navigate through expansion while keeping costs in check. Here are some key factors to consider when you’re making a plan and running the numbers.

The differences between on-grain and off-grain production involve much more than impact on flavor, and it pays for you to know the pros and cons of each method.

With estate grain and a climate-controlled rickhouse, Minden Mill’s team is exploring the impact of terroir on their spirits while taking a slow, measured approach to predicting how the environment impacts their maturation and flavor-focused blends.

American craft distillers have adapted an Old World practice for their varied production environments.

In this clip from their video course: Village Garage head distiller Ryan Scheswohl explains how steel-jacketed pipes and clean steam make for a quicker, more efficient brewing process.

A well-planned garden can provide a variety of fresh, vibrant flavors that bring cocktail syrups to the next level.

The strength at which distillers decide to bottle their products can have wide-ranging impact, from labeling laws to bartender preferences.

Understanding the dynamic way casks interact with the liquid inside and the environment around them is key to producing the components of a great whiskey blend.

From fermentation to infusion, distillers are finding unique approaches to tap into the fruits of the cactus.

Choosing between steam, direct-fire, electric, and oil-heated equipment is a matter of budget, taste, and local code enforcement.

A critical part of properly caring for stainless steel in the distillery is properly cleaning it, ensuring a long lifespan for the equipment as well as the safety of your team.

The master distiller for Alberta, Canada’s Black Velvet embraces the challenge of blending dynamically different distillates into a cohesive whole, with a process focused on consistency, quality, and repeatability.

A handful of distillers are looking to temper ABV without compromising flavor to provide something more for moderation-minded consumers.

Always popular when the weather gets hot, frozen drinks look simple enough but demand some know-how to get the best results.

Planning production in the distillery requires more than an optimistic foot on the gas. It demands a calculated look at production and sales capacity.

Get your bugout bag ready! In this special episode, co-hosts Molly Troupe and Sydney Jones reunite to swap advice with American Cane CEO Maggie Campbell and Jennifer Wren, an industry veteran who now specializes in coaching women on professional development.
By pitching expertly crafted yeast blends and experimenting to achieve the desired outcomes, distillers can unlock innovative flavors and differentiate their spirits from all the others on the shelf.

For most small-scale producers, batch-distilling is the standard approach to creating a variety of products.

Todd Leopold of Leopold Bros in Denver is part historian, part tinkerer, part creative muse, and part sounding board for the broader craft-distilling world—and his multi-stream approach to experimentation in the service of flavor over style is more relevant than ever.